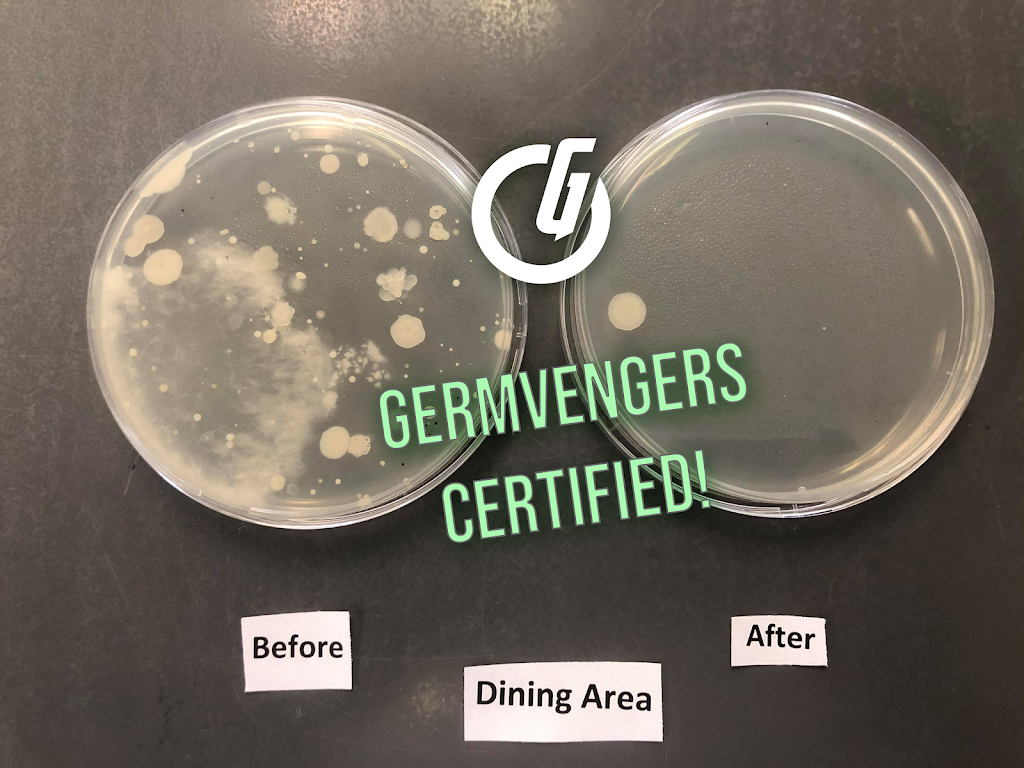

Germvengers Disinfection, Sanitation & Cleaning Services
(3 Reviews)
7345 Sandborne Ave #13, Burnaby, BC V3N 4W6, Canada
(778) 896-7176
Contact and Address
| Category: | Point of interest, Establishment, |
|---|---|
| Address: | 7345 Sandborne Ave #13, Burnaby, BC V3N 4W6, Canada |
| Postal code: | V3N 4W6 |
| Phone: | (778) 896-7176 |
| Website: | https://www.germvengers.ca/ |
Hours:
| Monday: | 9:00 AM – 9:00 PM |
|---|---|
| Tuesday: | 9:00 AM – 9:00 PM |
| Wednesday: | 9:00 AM – 9:00 PM |
| Thursday: | 9:00 AM – 9:00 PM |
| Friday: | 9:00 AM – 9:00 PM |
| Saturday: | 9:00 AM – 9:00 PM |
| Sunday: | 9:00 AM – 9:00 PM |
Location & routing
Get Directions
Most Recent Reviews
(June 23, 2020, 11:03 pm)Very professional disinfecting service company. I called few companies but they are the only one who gave me fair pricing and also able to schedule our clinic for the next day service. I highly recommend them!👍🏼
(June 20, 2020, 10:00 pm)My office desk at Yaletown never felt more clean and sanitized. Now I can work with ease and have peace of mind during my daily grind. They also told me the disinfectants were safe for people and pets, thank you Germvengers! Cool name! :D
(June 20, 2020, 4:32 pm)Good job! The house feels safer and cleaner after the work from Germvengers. Thanks!
Photos of Germvengers Disinfection, Sanitation & Cleaning Services